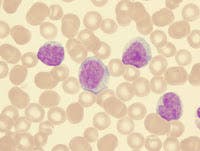

Health & Fitness
"Patient-Friendly" Advancement in Early Cancer Detection
Tested, proven & affordable cancer detection solution - just ask the Bedford Firefighters

"...the term 'cancer' is not a singular enemy; its a single term to represent hundreds of different cancer types-- all unique to their location in the body and their origin, and that makes screening/treating them a very specialized and a highly customized procedure." Howard Prince, research specialist & patient advocate.
Early detection and prevention pursuits have driven our medical community to invest heavily on the advancement of cancer screenings for every individual type of cancer. So exists specialized scanning processes and tools such as colonoscopy, tomography, mammograms, mri's, PSA tests, PET Scans, skin exams- just to name a few.
Recently, a new form of blood test by LAM (Laboratory for Advanced Medicine) called IvyGene can confirm the presence of cancer as early as stage 1. It provides measurable data in the form of a score to make it easier to understand- while confirming the presence of cancer early, when it can be more easily managed and treated. The score can be used as a baseline to measure treatment effectiveness.
Find out what's happening in New York Cityfor free with the latest updates from Patch.
CANCER INDICATORS FROM A "SIMPLE BLOOD TEST"
Among the growing list of cancer treatment professionals and practices who subscribe to IvyGene’ s innovative screening capacity is clinical immunologist Dr. Jesse Stoff of Integrative Medicine of NY in Westbury. As an integrative practitioner, Dr. Stoff is committed to staying on top of the latest in cancer treatment solutions available. "IvyGene is similar to a liquid biopsy in terms of the technology. It is based on next-gen technology & next-gen sequencing," says Dr. Stoff. "(For my purposes), I use this test for people who don't have signs of cancer because it takes on average 10 years for cancer to go from a few cancer cells into a destructive tumor. And during that 10 year period of time these abnormal cells are firing off pieces of genetic material into the blood stream as these cells die. And die they do because cancer cells are genetically unstable. That's part of the definition of cancer. The problem is they multiply faster than they die. So, that's how you get in trouble. As the cells die, they release material into the bloodstream that the IvyGene test is designed to pick up and act as an early warning where something is starting to grow someplace you need to pay attention to."
According to an interview with LAM representative Caleb Allen, "...our mission is to make cancer testing available and affordable for everyone. We work closely with thousands of physicians nationwide to provide early cancer confirmation and save lives sooner. Unlike many genetic tests that use DNA to determine the propensity or possibility of developing cancer over time, the IvyGene test confirms actual disease presence at the time of testing."
Find out what's happening in New York Cityfor free with the latest updates from Patch.
COMMON USES OF IVYGENE
Physicians who accepted the use of IvyGene to confirm cancer presence typically suggests it's use if the patient:
- has genetic propensity for development of cancer
- has suspicious imaging (PET, Mammo, CT) and needs confirmation
- has had cancer in the past, IvyGene monitors for remission
- is undergoing cancer treatment now
- is experiencing under-diagnosed health issues
SCIENCE: Using highly advanced technology, the team identified specific gene targets in human DNA that correlate with cancer presence. Then, the IvyGene technology measures certain ratios at those specific gene targets. This results in a simple score that is either (a) elevated and consistent with the presence of cancer or (b) “normal” and not consistent with cancer presence.
See video insert from Overview of theIvyGene Science
PUBLICLY AFFORDABLE & ACCESSIBLE
A recent trend in diagnostic lab services is the TESTING KIT- distributed to physicians and/or direct to the consumer. This innovative concept is changing the way health patients are getting treatment. Packaging lab testing services from one central location in the country through a portable (mailable) kit is a most cost effective and efficient way to gain public access to a specialized lab located anywhere in the country to partner with any clinic or practitioner. This streamlines the retrieval and delivery of acquired blood samples to the lab which greatly eliminates a number of additional steps leading to "overhead" expenses. Instead of building a major high-priced lab in each city, county or state, there is now just ONE central lab for the entire country- maintaining the level of consistency, accountability and accuracy of one facility, resulting in a dramatic cost benefit over a lab franchise all over the country. Where affordability greatly adds to the demand and public access, the "mailable testing kit" is quickly growing in many different diagnostic protocols.
CANCER DETECTION FOR FIREFIGHTERS
A firefighter's emergency rescue work often brings exposure to a wide range of hazardous (and potentially carcinogenic) substances. A recent study from the IAFF shows a significant percentage of firefighters will be diagnosed with cancer at some point during their lifetime. Others studies indicate that firefighters are up to 2X at risk for developing certain cancers. It is for this reason that 911CancerScan.com and its clinical partners including Integrative Medicine of NY helped to publicly introduce genetic testing protocols and such scanning/diagnostic innovations as the IvyGene solution to the community. Originally founded for 9/11 survivors and victims, the 911CancerScan program brings informational and resource access to any and all first responders to address this health risk.
See the Firefighter Cancer Support Network website for more information. Firefightercancersupport.org. Also see the recent report from WFAA, Dallas, regarding cancer and prevention policies for Firefighters: http://www.wfaa.com/article/ne...
...................................................................................................................................................................
DISCLAIMER:
This feature article is a non-commercial news presentation intended to provide topical news coverage and public reports with individuals pertaining to cancer diagnostic solutions. It's sole purpose is to present the intention of any/all products mentioned for public awareness and is not meant as a marketing endorsement in any way. Awareness for a Cure, the NY Cancer Resource Alliance, its' editors, producers, writers and sponsors (otherwise known as "publishers") take no liability for any results or statements published from/about the subject and does not provide any legal, technical, scientific or consultation advice through this article.